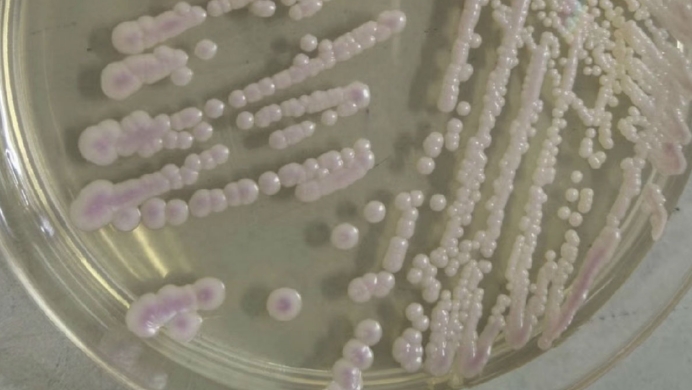
美国爆发真菌感染,美国出现罕见的真菌病了吗

美国再次出现“超级真菌”,已致3人死亡百人感染,这是什么真菌?
笔者 东邪
人类虽然站在食物链的顶端,但自然界和我们生存的环境中存在着一些肉眼难以发现的威胁因素,它们就是病毒和病菌。去年年初新冠病毒席卷全球,几乎每个大陆都陷入新冠疫情之中,不仅导致大规模的感染病例出现,全球经济也受到重创。美国作为世界大国之一也爆发了大规模疫情,该国的疫情目前还未得到控制。

一波未平一波又起,根据海外网7月23日的报道,美国疾病控制与预防中心于22日发布公告,指出近期美国华盛顿和达拉斯两地都出现了一种“超级真菌”感染疫情,目前已经导致上百人感染,3人死亡。据了解这已经不是美国第一次发生这种疫情,上一次比较严重的情况发生在2019年,导致上千人感染。

根据CDC官员的披露,这种“超级真菌”是一种名为“耳念球菌”的真菌,它具有很强的耐药性。那么美国这次的“真菌疫情”是怎么回事?耳念球菌是一种什么样的真菌?我们该如何预防这种真菌?
美国两地爆发“超级细菌”疫情是怎么回事?
根据CDC发布的报告显示,美国华盛顿特区一家疗养院和德克萨斯州达拉斯的两家医院都出现了耳念球菌感染病例,病例数量超过百起,目前已经导致3人死亡。根据这三家医院的医护人员描述,她们在对患者进行药物治疗时发现有少部分人表现出了对三种主要药物的完全耐药性,即药物无法发挥治疗效果,因此这部分患者的康复情况并不乐观。

而另一部分人则表现出对两种或一种药物的耐药性,因此还算有药可以进行医治。对于这种情况,CDC的研究人员梅根·莱曼表示这种现象源于耳念球菌的耐药性不同,有些耳念球菌对三种主要药物都有耐药性,有些耳念球菌只对一种药物表现出耐药性。此外,梅根指出通过对目前已发现的案例进行分析,她们发现几乎所有感染病例都是通过直接或间接接触造成的。

华盛顿和达拉斯共有123例感染病例,其中有5人被诊断存在耐药性,这五人中有3人已经死亡。由此可见,耳念球菌的致死率比较高,一旦患者出现耐药性,那么药物治疗基本没有效果。
耳念球菌是一种什么样的真菌?
虽然耳念球菌近几年在美国造成不少感染病例,但这种真菌最早是在日本被发现的。据悉,2009年日本科学家发现一种新的病原真菌物种,通过对感染病例以及真菌的研究,发现该真菌具有多重耐药性以及较高的致死率,因此将其称为“超级细菌”。耳念球菌被发现后,美国CDC将其列入“紧急威胁”名单中。
到了2019年4月,耳念球菌在美国多个地方爆发,发病案例达到600多起,当年中国国内也出现了18例感染病例,但没有爆发疫情。从目前的研究情况来看,绝大多数耳念球菌至少对一种抗真菌药物具有耐药性,三分之一以上的耳念球菌对两种抗真菌药物具有耐药性,部分耳念球菌对三种及以上的抗真菌药物具有耐药性。

根据CDC发布的研究数据显示,半数左右的感染者会在三个月内丧生,根本原因是这种真菌具有多重耐药性,在没有特效药的治疗下往往需要依靠个人的免疫力来战胜真菌。多数感染病例都发生在医院等环境中,患者最初的症状是发烧、疼痛和疲劳,当真菌扩散到血液、大脑和心脏时,会危及生命。
研究发现,感染耳念球菌的高风险人群是具有免疫问题或严重慢性基础疾病的患者,例如糖尿病、慢性肾病、艾滋病、癌症等。一般情况下,身体健康的人是不会感染这种真菌的。
耳念球菌的耐药性是如何出现的?有方法预防感染吗?
不同大陆上的耳念球菌表现出了不同的耐药性,这说明它们的耐药性是独立发展得到的。至于耳念球菌为什么具有耐药性,目前医学界没有统一的定论。但有理论认为,人类广泛在农业生产中使用杀菌剂导致耳念球菌的耐药性越来越强。也有观点认为是人类医学广泛使用抗生素,导致超级细菌的诞生。

大多数感染病例都发生在医院环境中,因此医院的环境以及医疗器械都需要进行充分的清洁和消毒。免疫力低下的人应该注意与他人的密切接触。